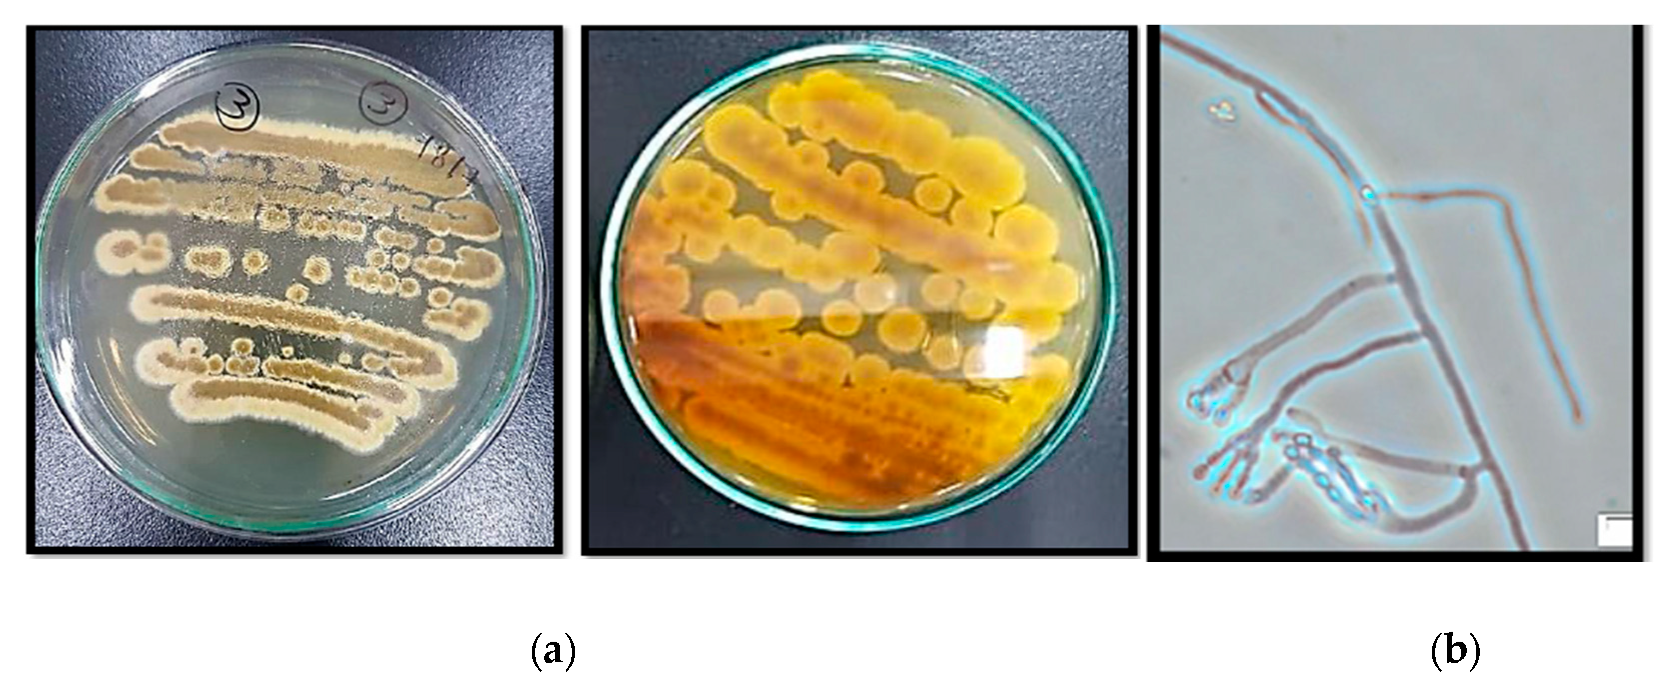
Molecules 24 04118 g001 Molecules 24 04118 g001

Bio-Guided Fractionation of Prenylated Benzaldehyde Derivatives as Potent Antimicrobial and Antibiofilm from Ammi majus L. Fruits-Associated Aspergillus amstelodami
Abstract
1. Introduction
2. Results
2.1. Isolation and Identification of the Endophytic Fungus
2.2. Identification and Elucidation of the Isolated Compounds
2.3. Antimicrobial Activity Screening
2.4. Antibiofilm Assay
2.5. Cytocompatibility
3. Discussion
4. Materials and Methods
4.1. Plant Material
4.2. Extraction of the Plant Material
4.3. Endophytic Fungi Isolation
4.4. Fungus Morphology and Microscopic Observation
4.5. Fungus Identification through Molecular Approach
4.6. Solid State Fermentation and Extraction of the Fungus Metabolites
4.7. Antimicrobial Susceptibility Assay for AME and FEA Extracts
4.8. Biofilm Inhibition Assay Using AME and FEA Extracts
4.9. Fractionation and Purification of FEA Extract Compounds
4.10. Antimicrobial Susceptibility and Biofilm Inhibition Assay Using FEA Fractions and Purified Compound
4.11. Cell Viability Determination
4.12. Statistical Analysis
5. Conclusions
Supplementary Materials
Author Contributions
Funding
Acknowledgments
Conflicts of Interest
References
- Mohammed, M.M.; El-Sharkawy, E.R. Cytotoxic new furoquinoline alkaloid isolated from Ammi majus L. growing in Egypt. Nat. Prod. Res. 2017, 31, 645–652. [Google Scholar] [CrossRef] [PubMed]
- Al-Snafi, A.E. Chemical constituents and pharmacological activities of Ammi majus and Ammi visnaga. A review. Int. J. Pharm. Ind. Res. 2013, 3, 257–265. [Google Scholar]
- Abdul-Jalil, T.Z.; Saour, K.; Nasser, A.-M. Phytochemical study of some flavonoids present in the fruits of two Ammi L. species wildly grown in Iraq. Iraqi J. Pharm. Sci. 2010, 19, 48–57. [Google Scholar]
- Narayanaswamy, R.; Ismail, I.S. Role of herbal medicines in vitiligo treatment-current status and future perspectives. Asian J. Pharm. Clin. Res. 2018, 11, 19–23. [Google Scholar] [CrossRef]
- Selim, Y.A.; Ouf, N.H. Anti-inflammatory new coumarin from the Ammi majus L. Org. Med. Chem. Lett. 2012, 2, 1. [Google Scholar] [CrossRef]
- Sharifi-Rad, J.; Soufi, L.; Ayatollahi, S.; Iriti, M.; Sharifi-Rad, M.; Varoni, E.M.; Shahri, F.; Esposito, S.; Kuhestani, K. Anti-bacterial effect of essential oil from Xanthium strumarium against shiga toxin-producing Escherichia coli. Cell. Mol. Biol. 2016, 62, 69–74. [Google Scholar]
- Azzimonti, B.; Cochis, A.; El Beyrouthy, M.; Iriti, M.; Uberti, F.; Sorrentino, R.; Landini, M.M.; Rimondini, L.; Varoni, E.M. Essential oil from berries of Lebanese Juniperus excelsa M. Bieb displays similar antibacterial activity to chlorhexidine but higher cytocompatibility with human oral primary cells. Molecules 2015, 20, 9344–9357. [Google Scholar] [CrossRef]
- Rodriguez, R.; White, J., Jr.; Arnold, A.E.; Redman, R. Fungal endophytes: Diversity and functional roles. New Phytol. 2009, 182, 314–330. [Google Scholar] [CrossRef]
- Nair, D.N.; Padmavathy, S. Impact of endophytic microorganisms on plants, environment and humans. Sci. World J. 2014, 2014, 250693. [Google Scholar] [CrossRef]
- Huang, Y.; Wang, J.; Li, G.; Zheng, Z.; Su, W. Antitumor and antifungal activities in endophytic fungi isolated from pharmaceutical plants Taxus mairei, Cephalataxus fortunei and Torreya grandis. FEMS Immunol. Med. Microbiol. 2001, 31, 163–167. [Google Scholar] [CrossRef]
- Phongpaichit, S.; Rungjindamai, N.; Rukachaisirikul, V.; Sakayaroj, J. Antimicrobial activity in cultures of endophytic fungi isolated from Garcinia species. FEMS Immunol. Med. Microbiol. 2006, 48, 367–372. [Google Scholar] [CrossRef] [PubMed]
- Sandhu, S.S.; Kumar, S.; Aharwal, R.P. Isolation and identification of endophytic fungi from Ricinus communis Linn. and their antibacterial activity. Int. J. Res. Pharm. Chem. 2014, 4, 611–618. [Google Scholar]
- Kamel, N.M.; Abdel-Motaal, F.F.; El-Zayat, S.A. Endophytic fungi from the medicinal herb Euphorbia geniculata as a potential source for bioactive metabolites. Arch. Microbiol. 2019, 1–9. [Google Scholar] [CrossRef] [PubMed]
- Chatterjee, S.; Ghosh, R.; Mandal, N.C. Production of bioactive compounds with bactericidal and antioxidant potential by endophytic fungus Alternaria alternata AE1 isolated from Azadirachta indica A. Juss. PLoS ONE 2019, 14, e0214744. [Google Scholar] [CrossRef]
- Costerton, J.W.; Cheng, K.J.; Geesey, G.G.; Ladd, T.I.; Nickel, J.C.; Dasgupta, M.; Marrie, T.J. Bacterial biofilms in nature and disease. Annu. Rev. Microbiol. 1987, 41, 435–464. [Google Scholar] [CrossRef]
- Costerton, J.W.; Stewart, P.S.; Greenberg, E.P. Bacterial biofilms: A common cause of persistent infections. Science 1999, 284, 1318–1322. [Google Scholar] [CrossRef]
- Sabu, R.; Soumya, K.R.; Radhakrishnan, E.K. Endophytic Nocardiopsis sp. from Zingiber officinale with both antiphytopathogenic mechanisms and antibiofilm activity against clinical isolates. 3 Biotech 2017, 7, 115. [Google Scholar] [CrossRef]
- Adham, A.N.; Abdulah, Z.A. Antibacterial and antibiofilm activity of Ammi majus seed against Gram-positive bacteria. Zanco J. Med. Sci. 2017, 21, 1664–1672. [Google Scholar] [CrossRef][Green Version]
- Araniti, F.; Lupini, A.; Mercati, F.; Statti, G.A.; Abenavoli, M.R. Calamintha nepeta L. (Savi) as source of phytotoxic compounds: Bio-guided fractionation in identifying biological active molecules. Acta Physiol. Plant. 2013, 35, 1979–1988. [Google Scholar] [CrossRef]
- Slater, G.P.; Macdonald, J.C.; Nakashima, R. Biosynthesis of echinulin by Aspergillus amstelodami from cyclo-L-alanyl-L-tryptophyl-14C. Biochemistry 1970, 9, 2886–2889. [Google Scholar] [CrossRef]
- Sun, K.; Wang, Y.; Fu, P.; Liu, P.; Zhu, W. Studies on the secondary metabolites of Eurotium herbariorum HT-2 symbiotic with Enteromorpha prolifera. Chin. J. Mar. Drugs 2013, 32, 37–45. [Google Scholar]
- Gao, J.; Radwan, M.M.; León, F.; Wang, X.; Jacob, M.R.; Tekwani, B.L.; Khan, S.I.; Lupien, S.; Hill, R.A.; Dugan, F.M. Antimicrobial and antiprotozoal activities of secondary metabolites from the fungus Eurotium repens. Med. Chem. Res. 2012, 21, 3080–3086. [Google Scholar] [CrossRef] [PubMed]
- Miyake, Y.; Ito, C.; Kimura, T.; Suzuki, A.; Nishida, Y.; Itoigawa, M. Isolation of aromatic compounds produced by Eurotium herbariorum NU-2 from karebushi, a katsuobushi, and their DPPH-radical scavenging activities. Food Sci. Technol. Res. 2014, 20, 139–146. [Google Scholar] [CrossRef]
- Elissawy, A.M.; Ebada, S.S.; Ashour, M.L.; Singab, A.B. A Comparative Chemical Study of the Bioactive Secondary Metabolites Isolated from Red Sea Organisms and the Associated Fungi. Ph.D. Thesis, Pharmacognosy Department, Faculty of Pharmacy, Ain Shams University, Cairo, Egypt, 2017. [Google Scholar]
- Elissawy, A.M.; Ebada, S.S.; Ashour, M.L.; El-Neketi, M.; Ebrahim, W.; Singab, A.B. New secondary metabolites from the mangrove-derived fungus Aspergillus sp. AV-2. Phytochem. Lett. 2019, 29, 1–5. [Google Scholar] [CrossRef]
- Palacio-Barrera, A.M.; Areiza, D.; Zapata, P.; Atehortúa, L.; Correa, C.; Peñuela-Vásquez, M. Induction of pigment production through media composition, abiotic and biotic factors in two filamentous fungi. Biotechnol. Rep. 2019, 21, e00308. [Google Scholar] [CrossRef] [PubMed]
- Quilico, A.; Panizzi, L. Chemische Untersuchungen über Aspergillus echinulatus, I. Mitteilung. Ber. Dtsch. Chem. Ges. (A B Ser.) 1943, 76, 348–358. [Google Scholar] [CrossRef]
- Quilico, A.; Panizzi, L.; Mugnaini, E. Structure of flavoglaucin and auroglaucin. Nature 1949, 164, 26–27. [Google Scholar] [CrossRef]
- Ishikawa, Y.; Morimoto, K.; Hamasaki, T. Flavoglaucin, a metabolite of Eurotium chevalieri, its antioxidation and synergism with tocopherol. J. Am. Oil Chem. Soc. 1984, 61, 1864–1868. [Google Scholar] [CrossRef]
- Kawai, K.; Mori, H.; Kitamura, J. The uncoupling effect of flavoglaucin, a quinol pigment from Aspergillus chevalieri (Mangin), on mitochondrial respiration. Toxicol. Lett. 1983, 19, 321–325. [Google Scholar] [CrossRef]
- Nazar, M.; Ali, M.; Fatima, T.; Gubler, C. Toxicity of flavoglaucin from Aspergillus chevalieri in rabbits. Toxicol. Lett. 1984, 23, 233–237. [Google Scholar] [CrossRef]
- Al-Hadhrami, R.M.S.; Hossain, M.A. Evaluation of antioxidant, antimicrobial and cytotoxic activities of seed crude extracts of Ammi majus grown in Oman. Egypt. J. Basic Appl. Sci. 2016, 3, 329–334. [Google Scholar] [CrossRef][Green Version]
- Hussein, H.M.; Hameed, I.H.; Ubaid, J.M. Analysis of the secondary metabolite products of Ammi majus and evaluation anti-insect activity. Int. J. Pharmacogn. Phytochem. Res. 2016, 8, 1403–1411. [Google Scholar]
- Al-Hadhrami, R.M.S.; Al Muniri, R.M.S.; Hossain, M.A. Evaluation of antimicrobial and cytotoxic activities of polar solvent extracts from leaves of Ammi majus used by the omanis. Pac. Sci. Rev. A Nat. Sci. Eng. 2016, 18, 62–65. [Google Scholar] [CrossRef][Green Version]
- Santos, I.P.D.; Silva, L.C.N.D.; Silva, M.V.D.; Araújo, J.M.D.; Cavalcanti, M.D.S.; Lima, V.L.D.M. Antibacterial activity of endophytic fungi from leaves of Indigofera suffruticosa Miller (Fabaceae). Front. Microbiol. 2015, 6, 350. [Google Scholar] [CrossRef] [PubMed]
- Darling, W.; Campbell, P.; McARDLE, M. Antibiotics from Aspergillus amstelodami. Microbiology 1963, 33, 191–204. [Google Scholar] [CrossRef] [PubMed]
- Marchelli, R.; Dossena, A.; Pochini, A.; Dradi, E. The structures of five new didehydropeptides related to neoechinulin, isolated from Aspergillus amstelodami. J. Chem. Soc. Perkin Trans. 1 1977, 1, 713–717. [Google Scholar] [CrossRef]
- Slack, G.J.; Puniani, E.; Frisvad, J.C.; Samson, R.A.; Miller, J.D. Secondary metabolites from Eurotium species, Aspergillus calidoustus and A. insuetus common in Canadian homes with a review of their chemistry and biological activities. Mycol. Res. 2009, 113, 480–490. [Google Scholar] [CrossRef]
- VanderMolen, K.M.; Raja, H.A.; El-Elimat, T.; Oberlies, N.H. Evaluation of culture media for the production of secondary metabolites in a natural products screening program. AMB Express 2013, 3, 71. [Google Scholar] [CrossRef]
- Porras-Alfaro, A.; Bayman, P. Hidden fungi, emergent properties: Endophytes and microbiomes. Annu. Rev. Phytopathol. 2011, 49, 291–315. [Google Scholar] [CrossRef]
- Wu, M.-D.; Cheng, M.-J.; Hsieh, S.-Y.; Yuan, G.-F. Chemical constituents of the fungus of Eurotium chevalieri BCRC 07F0022. Chem. Nat. Compd. 2014, 49, 1175–1176. [Google Scholar] [CrossRef]
- Lemos, A.S.O.; Campos, L.M.; Melo, L.; Guedes, M.C.M.R.; Oliveira, L.G.; Silva, T.P.; Melo, R.C.N.; Rocha, V.N.; Aguiar, J.A.K.; Apolônio, A.C.M.; et al. Antibacterial and antibiofilm activities of psychorubrin, a pyranonaphthoquinone isolated from Mitracarpus frigidus (Rubiaceae). Front. Microbiol. 2018, 9, 724. [Google Scholar] [CrossRef] [PubMed]
- Fatima, S.; Prasanthi, K.; Nagamani, K. Comparative evaluation of biofilm production in multidrug resistant and sensitive Gram negative clinical isolates. Int. J. Curr. Microbiol. Appl. Sci. 2015, 4, 918–926. [Google Scholar]
- Lewis, K. Riddle of biofilm resistance. Antimicrob. Agents Chemother. 2001, 45, 999–1007. [Google Scholar] [CrossRef] [PubMed]
- Costerton, J.W. Introduction to biofilm. Int. J. Antimicrob. Agents 1999, 11, 217–221. [Google Scholar] [CrossRef]
- De la Fuente-Núñez, C.; Reffuveille, F.; Fernández, L.; Hancock, R.E. Bacterial biofilm development as a multicellular adaptation: Antibiotic resistance and new therapeutic strategies. Curr. Opin. Microbiol. 2013, 16, 580–589. [Google Scholar] [CrossRef] [PubMed]
- Magiorakos, A.-P.; Srinivasan, A.; Carey, R.; Carmeli, Y.; Falagas, M.E.; Giske, C.; Harbarth, S.; Hindler, J.; Kahlmeter, G.; Olsson-Liljequist, B.; et al. Multidrug-resistant, extensively drug-resistant and pandrug-resistant bacteria: An international expert proposal for interim standard definitions for acquired resistance. Clin. Microbiol. Infect. 2012, 18, 268–281. [Google Scholar] [CrossRef] [PubMed]
- Matsumoto-Nakano, M. Role of Streptococcus mutans surface proteins for biofilm formation. Jpn. Dent. Sci. Rev. 2018, 54, 22–29. [Google Scholar] [CrossRef]
- Brahma, U.; Kothari, R.; Sharma, P.; Bhandari, V. Antimicrobial and anti-biofilm activity of hexadentated macrocyclic complex of copper (II) derived from thiosemicarbazide against Staphylococcus aureus. Sci. Rep. 2018, 8, 8050. [Google Scholar] [CrossRef]
- Kelly, D.; McAuliffe, O.; Ross, R.; Coffey, A. Prevention of Staphylococcus aureus biofilm formation and reduction in established biofilm density using a combination of phage K and modified derivatives. Lett. Appl. Microbiol. 2012, 54, 286–291. [Google Scholar] [CrossRef]
- Nobile, C.J.; Johnson, A.D. Candida albicans biofilms and human disease. Annu. Rev. Microbiol. 2015, 69, 71–92. [Google Scholar] [CrossRef]
- Hazalin, N.A.; Ramasamy, K.; Lim, S.M.; Wahab, I.A.; Cole, A.L.; Majeed, A.B.A. Cytotoxic and antibacterial activities of endophytic fungi isolated from plants at the National Park, Pahang, Malaysia. BMC Complement. Altern. Med. 2009, 9, 46. [Google Scholar] [CrossRef] [PubMed]
- Hubka, V.; Kubátová, A.; Peterson, S.W.; Kolařík, M. Taxonomic revision of Eurotium and transfer of species to Aspergillus. Mycologia 2013, 105, 912–937. [Google Scholar] [CrossRef] [PubMed]
- Turan, C.; Nanni, I.M.; Brunelli, A.; Collina, M. New rapid DNA extraction method with Chelex from Venturia inaequalis spores. J. Microbiol. Methods 2015, 115, 139–143. [Google Scholar] [CrossRef] [PubMed]
- Morgan, M.C.; Boyette, M.; Goforth, C.; Sperry, K.V.; Greene, S.R. Comparison of the Biolog OmniLog Identification System and 16S ribosomal RNA gene sequencing for accuracy in identification of atypical bacteria of clinical origin. J. Microbiol. Methods 2009, 79, 336–343. [Google Scholar] [CrossRef]
- Simpson, A.J.G.; Reinach, F.C.; Arruda, P.; Abreu, F.A.; Acencio, M.; Alvarenga, R.; Alves, L.M.C.; Araya, J.E.; Baia, G.S.; Baptista, C.S.; et al. The genome sequence of the plant pathogen Xylella fastidiosa. Nature 2000, 406, 151–157. [Google Scholar] [CrossRef]
- Christophersen, C.; Crescente, O.; Frisvad, J.C.; Gram, L.; Nielsen, J.; Nielsen, P.H.; Rahbæk, L. Antibacterial activity of marine-derived fungi. Mycopathologia 1998, 143, 135–138. [Google Scholar] [CrossRef]
- Tunney, M.M.; Ramage, G.; Field, T.R.; Moriarty, T.F.; Storey, D.G. Rapid Colorimetric Assay for antimicrobial susceptibility testing of Pseudomonas aeruginosa. Antimicrob. Agents Chemother. 2004, 48, 1879–1881. [Google Scholar] [CrossRef]
- Ramage, G.; Walle, K.V.; Wickes, B.L.; López-Ribot, J.L. Standardized method for in vitro antifungal susceptibility testing of Candida albicans biofilms. Antimicrob. Agents Chemother. 2001, 45, 2475–2479. [Google Scholar] [CrossRef]
- Haney, E.; Trimble, M.; Cheng, J.; Vallé, Q.; Hancock, R. Critical assessment of methods to quantify biofilm growth and evaluate antibiofilm activity of host defense peptides. Biomolecules 2018, 8, 29. [Google Scholar] [CrossRef]
- Vichai, V.; Kirtikara, K. Sulforhodamine B colorimetric assay for cytotoxicity screening. Nat. Protoc. 2006, 1, 1112–1116. [Google Scholar] [CrossRef]
Sample Availability: Samples of the compounds are not available from the authors. |

| Morphological Characters | Microscopic Characters | ||
|---|---|---|---|
| Surface | Yellowish Green | Hyphae | Branched septate |
| Margins | Entire | Conidia | Yellowish green (4 to 7 μm), roughened |
| Reverse side | Brownish yellow | Phialides | Single series (Uniseriate) covering nearly the entire vesicle |
| Growth | Slow to moderate | ||
| Elevations | Umbonate | ||
| 1 | 2 | 3 | 4 | 5 | ||||
|---|---|---|---|---|---|---|---|---|
| Atom no | δH,1H-NMR | δC13C-NMR/APT | δH, 1H-NMR | δC13C-NMR/APT | δH, 1H-NMR | δH, 1H-NMR | δH, 1H-NMR | δC13C-NMR/APT |
| 1 | - | 130.8 C | - | 117.5 C | - | - | - | 115 C |
| 2 | - | 127.5 C | - | 123.8 C | - | - | - | 128.8 C |
| 3 | - | 145.5 C | - | 145.2 C | - | - | - | 144.8 C |
| 4 | 7.0 (s), 1H | 125.7 CH | 7.04 (s), 1H | 125.3 CH | 7.02 (s), 1H | 6.36 (m), 1H | 6.9 (s), 1H 4.6 (s), OH | 125.4 CH |
| 5 | - | 135.8 C | - | 130.3 C | - | - | - | 133.6 C |
| 6 | 11.75 (s), OH | 158.5 C | 11.77 (s)OH | 155.6 C | 11.95 (s), OH | 11.83 (s), 1H | 11.95 (s), OH | 154.8 C |
| 7 | 10.1 (s) | 196.5 CH | 10.2 (s), 1H | 196.7 CH | 10.3 (s), 1H | 10.12 (S), 1H | 10.3 (s), 1H | 195.9 CH |
| 1′ | 6.59 (d, J = 15.8 Hz, 1H) | 140.7 CH | 6.50 (d, J = 16.1 Hz, 1H) | 121.05 CH | 6.92 (d, J = 5.5 Hz, 1H) | 2.99 (m), 2H | 2.9 (m), 2H | 24.7 CH2 |
| 2′ | 6.46 (dd, J = 15.8, 10.1 Hz, 1H) | 132.19 CH | 6 (m). 1H | 142.8 CH | 6 (m), 1H | 1.6 (m), 2H | 1.6 (m), 2H | 32.07 CH2 |
| 3′ | 6.3 (m), 1H | 125.49 CH | 2.3 (m), 2H | 34.03 CH2 | 5.3 (m), 1H | 1.4 (m),2H | 1.4 (m), 2H | 29.7 CH2 |
| 4′ | 5.47 (m), 1H | 119.9 CH | 1.5 (m), 2H | 28.9 CH2 | 6.1 (m), 1H | 1.3 (m), 1H | 1.31 (m), 2H | 29.1 CH2 |
| 5′ | 2.1 (m), 2H | 34.9 CH2 | 1.4 (m), 2H | 31.47 CH2 | 6.1 (m), 2H | 5.3 (m),1H | 1.38 (m), 2H | 31.7 CH2 |
| 6′ | 1.3 (m), 2H | 29.9 CH2 | 1.3 (m), 2H | 22.2 CH2 | 1.29 (m), 1H | 5.4 (m), 1H | 1.29 (m), 2H | 22.7 CH2 |
| 7′ | 0.9 (m), 3H | 13.40 CH3 | 0.94 (m), 3H | 14.3 CH3 | 1.3 (m), 3H | 1.86 (d, J = 1.6 Hz, 1H) | 0.9 (m), 3H | 14 CH3 |
| 1″ | 3.34 (d, J = 7.8 Hz, 1H) | 27.1 CH2 | 3.34 (d, J = 7.4 Hz, 2H) | 27.18 CH3 | 3.32 (d, J = 7.4 Hz, 1H) | 3.44 (d, J = 7.6 Hz, 1H) | 3.31 (d, J = 7.5 Hz, 1H) | 27.02 CH2 |
| 2″ | 5.3 (m), 1H | 121.2 CH | 5.3 (m), 1H | 120.5 CH | 5.3 (m), 1H | 5.88 (m), 1H | 5.3 (m), 1H | 121.2 CH |
| 3″ | - | 139.8 CH | - | 133.8 C | - | - | - | 133.9 C |
| 4″ | 1.7 (s), 3H | 17.7 CH3 | 1.7 (s), 3H | 18.29 CH3 | 1.7 (s), 3H | 1.75 (s), 3H | 1.7 (s), 3H | 17.7 CH3 |
| 5″ | 1.8 (s), 3H | 25.9 CH3 | 1.8 (s), 3H | 25.7 CH3 | 1.8 (s), 3H | 1.85 (s), 3H | 1.8 (s), 3H | 25.7 CH3 |
© 2019 by the authors. Licensee MDPI, Basel, Switzerland. This article is an open access article distributed under the terms and conditions of the Creative Commons Attribution (CC BY) license (http://creativecommons.org/licenses/by/4.0/).
Share and Cite
Fathallah, N.; Raafat, M.M.; Issa, M.Y.; Abdel-Aziz, M.M.; Bishr, M.; Abdelkawy, M.A.; Salama, O. Bio-Guided Fractionation of Prenylated Benzaldehyde Derivatives as Potent Antimicrobial and Antibiofilm from Ammi majus L. Fruits-Associated Aspergillus amstelodami. Molecules 2019, 24, 4118. https://doi.org/10.3390/molecules24224118
Fathallah N, Raafat MM, Issa MY, Abdel-Aziz MM, Bishr M, Abdelkawy MA, Salama O. Bio-Guided Fractionation of Prenylated Benzaldehyde Derivatives as Potent Antimicrobial and Antibiofilm from Ammi majus L. Fruits-Associated Aspergillus amstelodami. Molecules. 2019; 24(22):4118. https://doi.org/10.3390/molecules24224118
Chicago/Turabian StyleFathallah, Noha, Marwa M. Raafat, Marwa Y. Issa, Marwa M. Abdel-Aziz, Mokhtar Bishr, Mostafa A. Abdelkawy, and Osama Salama. 2019. "Bio-Guided Fractionation of Prenylated Benzaldehyde Derivatives as Potent Antimicrobial and Antibiofilm from Ammi majus L. Fruits-Associated Aspergillus amstelodami" Molecules 24, no. 22: 4118. https://doi.org/10.3390/molecules24224118
APA StyleFathallah, N., Raafat, M. M., Issa, M. Y., Abdel-Aziz, M. M., Bishr, M., Abdelkawy, M. A., & Salama, O. (2019). Bio-Guided Fractionation of Prenylated Benzaldehyde Derivatives as Potent Antimicrobial and Antibiofilm from Ammi majus L. Fruits-Associated Aspergillus amstelodami. Molecules, 24(22), 4118. https://doi.org/10.3390/molecules24224118

